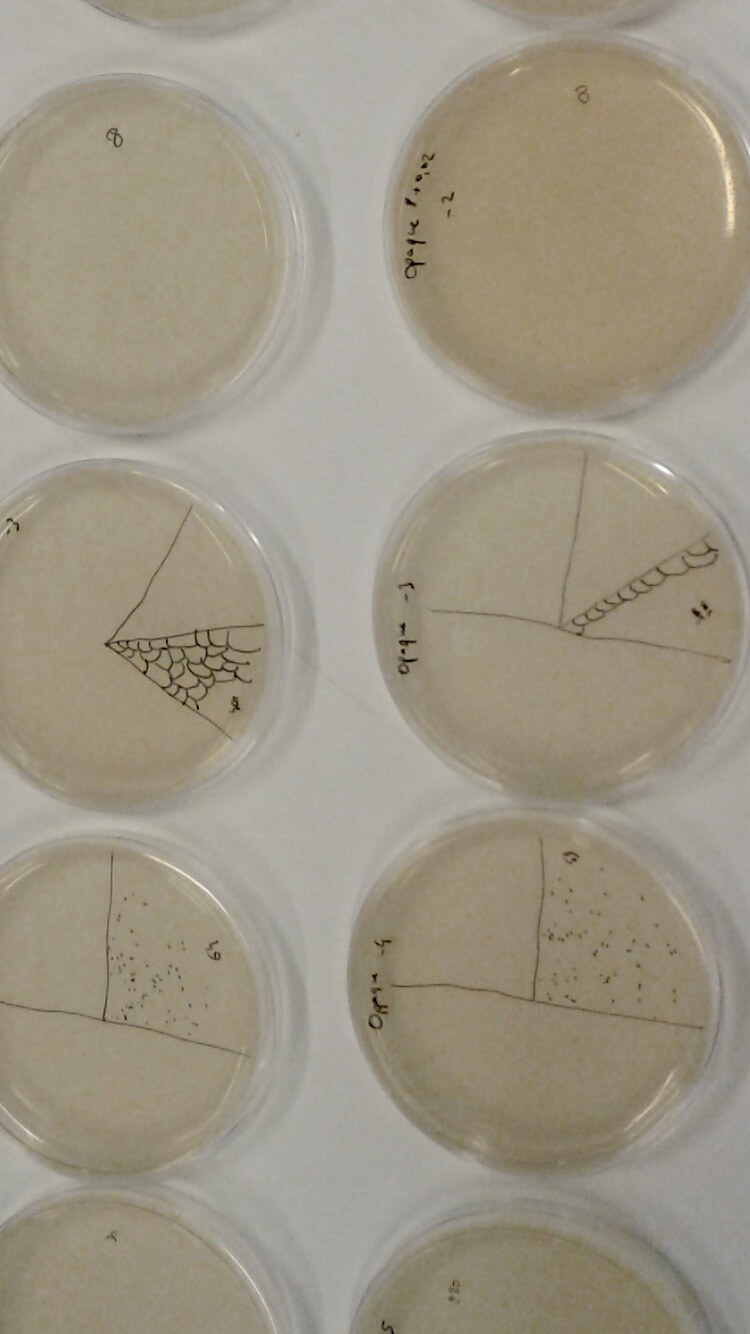
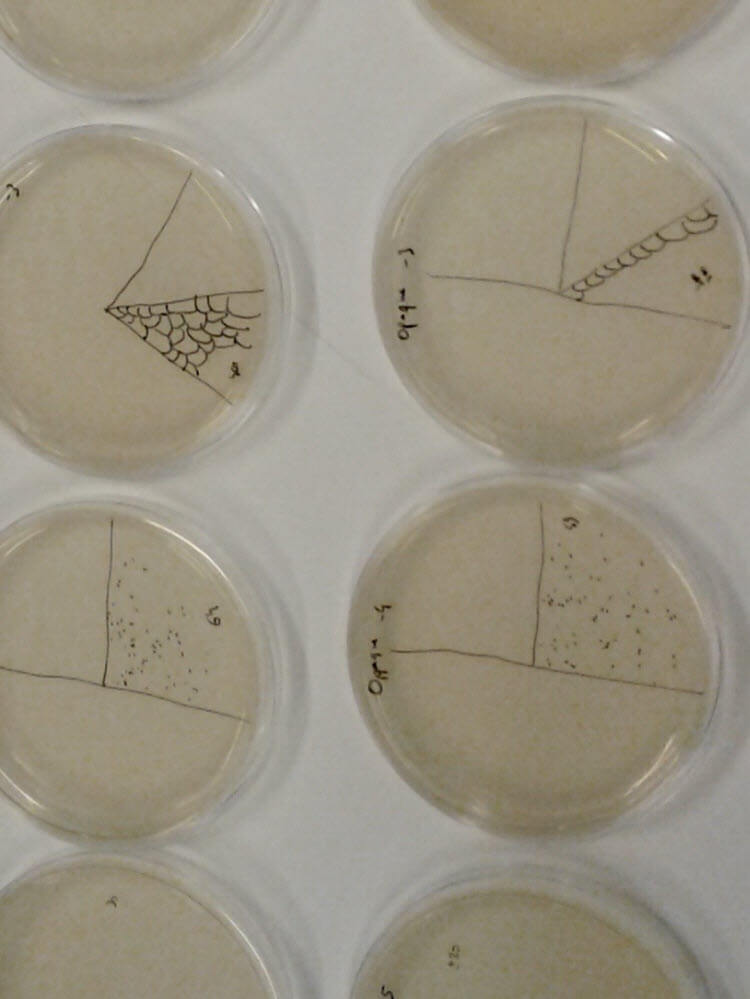

Rosie Broadhead, a recent master’s graduate from Central Saint Martins, speaks to Jessica Owen about her newest designs that encapsulate bacteria to nourish the body
-


Applications include sports, outdoor activites and general self-care
-

The probiotics within the garments help promote cell renewal and protect against skin conditions
Sign up today to access your 2 free (insight) articles this month, along with many other benefits.
-
Registered
Stay informed with limited access to global innovation news throughout the textile and apparel value chain.
The journey starts here....
- Weekly ICYMI (in case you missed it) email ? Our weekly round-up of content delivered to your inbox.
- Insight (limited) ? Feature-length articles providing significant insights into crucial industry developments, material, technology innovation and business innovation, includes direct-to-source interviews with key industry stakeholders and market roundups.
- News ? Press releases from across the global textile & apparel supply chain, bringing you all the latest developments direct from the companies involved.
- Sponsored Content ? Sponsored editorial with companies and organisations within the textile & apparel supply chain, based on company developments, product launches and key initiatives.
- Podcast ? Immerse yourself in the latest innovations and expert insights from global textile and apparel leaders—spanning Asia to the Americas—covering the full value chain from tech to manufacturing.
- Digital Journals (limited) ? Our current and archived digital journals.
-
Member
Deepen your understanding of key trends, technologies, and developments shaping the textile and apparel industry.
Everything in 'Registered' and....
- Insight (unlimited) ? Feature-length articles providing significant insights into crucial industry developments, material, technology innovation and business innovation, includes direct-to-source interviews with key industry stakeholders and market roundups.
- Watchlist ? Build bespoke email alerts using keywords, schedule frequency, and delivery timing.
- Virtual event pass (1 per member) ? Attend our virtual events that explore and celebrate innovation right across the textile and apparel value chain.
- Event reports ? Comprehensive digital event reports created after our virtual events, dive deep into key topics discussed during the event.
- Email support ? We're here to help.
-
Member Plus
Access expert analysis, actionable intelligence, and vital content to help you uncover, understand, and innovate.
Everything in 'Member' and....
- Intelligence ? Business-critical content, sometimes incorporating proprietary data and analysis, with a strategic focus on business, material and/or technology innovation. Often more in-depth and technical, this content type identifies opportunities, market shits and potential impact.
- Case studies ? Structured insights into challenges faced by manufacturing facilities and the solutions they have adopted. Each article includes business insights, problems, solutions, technologies, measurables, outcomes and learnings.
- Innovation Briefings ? Articles providing an academic and commercial perspective on key topics and innovations, including both emerging or commercially ready innovations.
- Company profiles ? In-depth reports offering structured analysis on the strategic activities of companies within the textile & apparel supply chain.
- Funding watch articles ? Monthly roundup and assessment of the past month's venture funding news within the textile & apparel supply chain, focusing on early and growth stage funding.
- Reports ? In-depth editorial reports on key sectors, events and topic. Includes insight, market-driven developments, interviews and analysis in a comprehensive, journal format.
- Pricing ? Access to our weekly EMR (Executive Market Report) and WMR (Wool Market Report) pricing reports.
- 10% discount on consultancy ? Unlock your next growth phase and discover new opportunities by leveraging our bespoke consultancy service. WTiN has been commissioned by its consultancy clients for almost 10 years, all taking advantage of our over 100 years of history in the textile & apparel industry.
- Email support ? We're here to help.
-
Member Premium
Use proprietary data tools to track, monitor, analyse and navigate industry trends and market shifts with confidence.
Everything in 'Member plus' and....
- Digital Textiles Market Tracker ? Proprietary data and analysis of global digital textiles market sales.
- Patents
- Fibres Hub ? The number of on-demand videos you can show on your booth
- Smart Textiles Database
- Additional virtual event passes ? Additional passes for your colleagues and select customers beyond the named members.
- Custom data feeds ? We can work with you do deliver our data to you in the format you need.
- 20% discount on consultancy ? Unlock your next growth phase and discover new opportunities by leveraging our bespoke consultancy service. WTiN has been commissioned by its consultancy clients for almost 10 years, all taking advantage of our over 100 years of history in the textile & apparel industry.
- Email & phone support ? We're here to help
Unlock a bespoke solution-based membership proposal, just for you...
Already have an account? Log In

